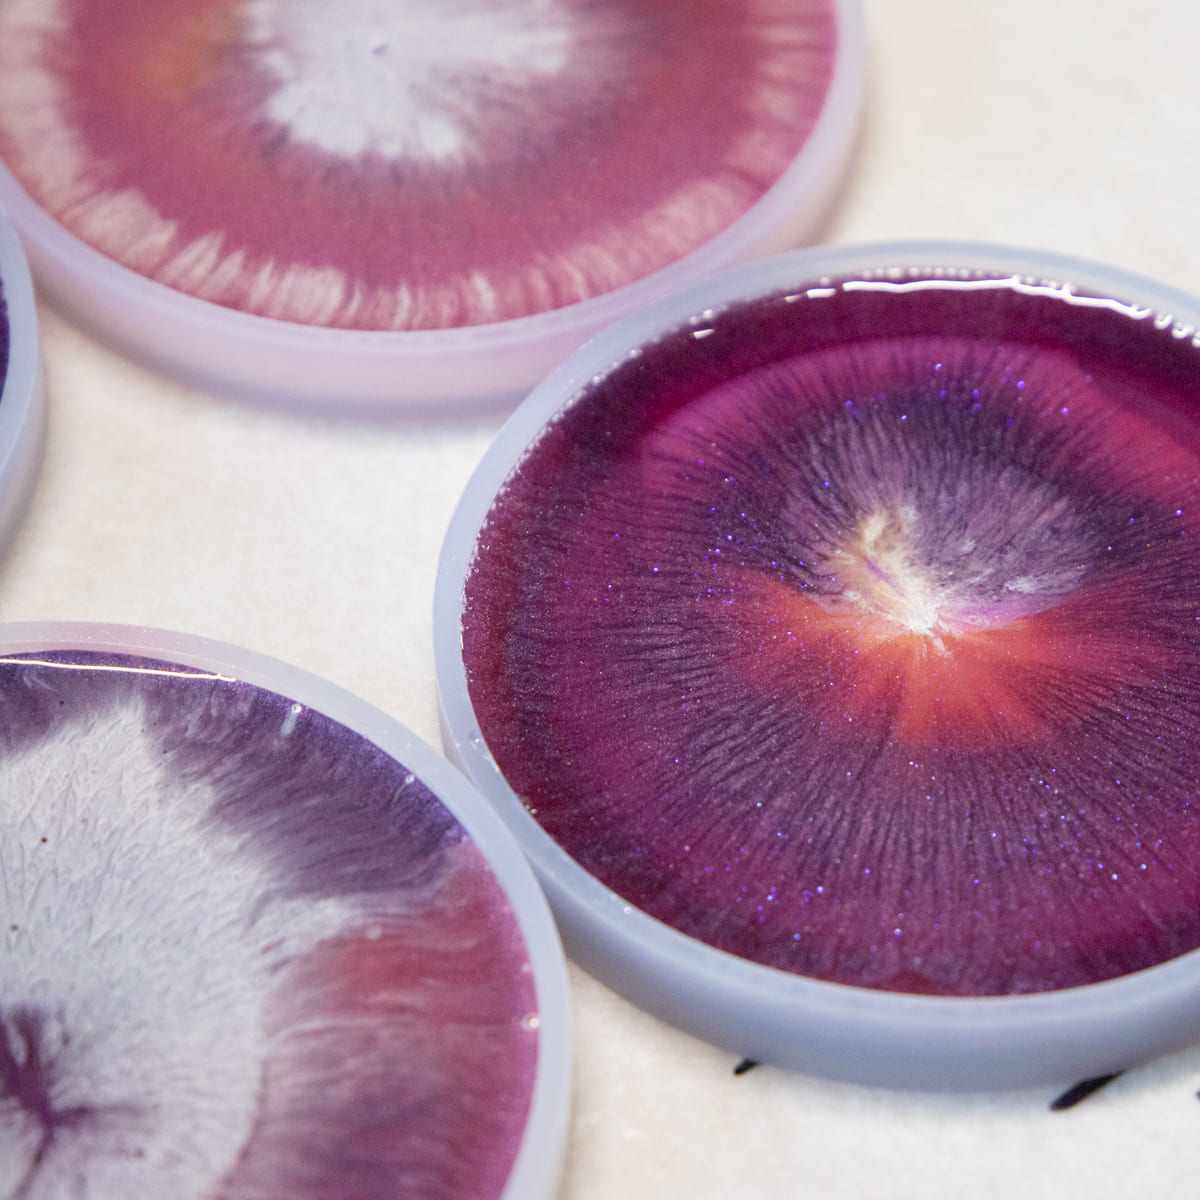

Epoxy is de laatste jaren enorm populair geworden onder creatievelingen. Het is veelzijdig, kleurrijk en biedt eindeloze mogelijkheden om unieke kunstwerken te maken. Speciaal voor beginners heeft Epoxywinkel een complete epoxy workshop ontwikkeld waarin je op een veilige en toegankelijke manier leert gieten met epoxy. Je ontdekt stap voor stap hoe het materiaal werkt en je maakt tijdens de workshop jouw eigen set epoxy onderzetters. Alle materialen komen uit het assortiment van Epoxywinkel zodat je precies leert werken met producten die je later ook zelf kunt bestellen.
Wat je leert tijdens de epoxy workshop
Tijdens de workshop maak je kennis met epoxy giethars en leer je hoe hars en verharder samen reageren. De trainer laat zien hoe je de juiste mengverhouding gebruikt en hoe je mengt zonder luchtbelletjes te creëren. Vervolgens ga je zelf aan de slag met pigmenten en metallic poeders. Je leert kleuren combineren en effecten maken die passen bij jouw ontwerp. Onder begeleiding giet je jouw eigen set onderzetters in speciale mallen. Je leert hoe je kleine foutjes herstelt en hoe je de onderzetters strak afwerkt.
Omdat epoxy minimaal een dag moet uitharden, worden jouw onderzetters na de workshop op locatie gecontroleerd. De eerste onderzetter wordt voorzichtig uit de mal gehaald zodat Epoxywinkel kan beoordelen of het resultaat correct is uitgehard. De overige onderzetters blijven in de mal zodat jij ze thuis zelf kunt ontmallen, het leukste moment van het hele proces. Zodra alles volledig is uitgehard, worden jouw creaties netjes naar je opgestuurd.
Waarom kiezen voor de epoxy workshop van Epoxywinkel
De workshop werkt volledig met materialen uit het eigen assortiment. Dat betekent dat je niet alleen leert hoe je met epoxy werkt, maar ook hoe je deze exacte producten thuis kunt gebruiken. De workshop is ontwikkeld voor beginners, met duidelijke uitleg en persoonlijke begeleiding. In ongeveer twee uur ontvang je zowel theoretische kennis als praktische vaardigheden. Je krijgt alle materialen uit het Flow Resin Onderzetter pakket mee naar huis, als je dat wilt, zodat je direct verder kunt oefenen. De workshop combineert creativiteit, vakkennis en hoogwaardige materialen waardoor je met vertrouwen verder aan de slag kunt.
Hoe de workshop verloopt
De ontvangst
Je komt binnen in de workshopruimte in Diemen en begint rustig met koffie of thee. Ondertussen maak je kennis met de trainer en de andere deelnemers. Zodra iedereen aanwezig is start de introductie over veiligheid en basiskennis.
Veilig werken
De trainer legt uit hoe je veilig met epoxy werkt. Je krijgt handschoenen, een schort en instructies over ventilatie en het vermijden van huidcontact. Wil je meer lezen over veiligheid dan kun je de handleiding bekijken genaamd Veilig werken met epoxy giethars.
Mengen en voorbereiden
Vervolgens leer je hoe je giethars en verharder in de juiste verhouding mengt. Je ontdekt hoe verwerkingstijd werkt en hoe je voorkomt dat er luchtbelletjes in het mengsel ontstaan.
Kleuren en effecten
Daarna ga je aan de slag met pigmenten en metallic poeders. Je leert hoe je kleuren kunt mengen en patronen kunt creëren die passen bij jouw persoonlijk ontwerp.
Gieten van de onderzetters
Met behulp van onderzettermallen giet je jouw ontwerpen. Je krijgt tips om luchtbelletjes te verwijderen en een glad resultaat te bereiken. De trainer loopt rond voor persoonlijke ondersteuning.
Uitharden en verzending
De creaties blijven achter om volledig uit te harden. Na de uitharding worden ze zorgvuldig verpakt en naar je toegestuurd. Zo ontvang je jouw eigen kunstwerk in perfecte staat.
Wat je mee naar huis krijgt
Aan het einde van de workshop neem je alle materialen van het Flow Resin Onderzetter pakket mee zoals mengbekers, roerstaafjes en handschoenen. Je krijgt herbruikbare mallen en eventuele resterende epoxy mee zodat je thuis direct verder kunt experimenteren. De onderzetters worden later naar je verzonden zodat je ze volledig uitgehard en in de beste kwaliteit ontvangt.
Wanneer en waar je de epoxy workshop kunt volgen
De epoxy workshop vindt plaats in Diemen en wordt meerdere keren per week gegeven. Doordeweeks kun je kiezen tussen 15.00 of 19.00 uur. In het weekend zijn er workshops om 10.00, 15.00 of 19.00 uur. De workshop duurt gemiddeld twee uur. Ben je op zoek naar een epoxy workshop in Noord Holland dan zit je hier helemaal goed. Via de knop Check beschikbaarheid op de website zie je direct welke momenten nog vrij zijn.
Kledingadvies
Epoxy kan permanente vlekken veroorzaken. Daarom is het verstandig om kleding te dragen die vies mag worden. Epoxywinkel zorgt voor schorten en handschoenen maar een extra laag bescherming voorkomt stress tijdens het gieten.
Ervaringen van deelnemers
Geweldige workshop
Een deelnemer schreef dat de epoxy workshop een feestje was. Alles liep soepel, de uitleg was duidelijk en iedereen had binnen korte tijd de techniek onder de knie. De quiz tussendoor zorgde voor ontspanning en een leuke sfeer in de groep.
Top workshop
Een andere deelnemer benoemde dat de uitleg over het mengproces en de pigmenten helder was en zorgde voor een echt aha moment. Vanaf het begin tot het einde was het genieten en de deelnemer was blij dat hij had meegedaan.
Wil je meer doen met epoxy? Bekijk onze handleidingen
Ben je na de workshop geïnspireerd om thuis verder te gieten dan kun je onze uitgebreide handleidingen bekijken. Denk aan Resin bookmarks maken, Epoxy canvas art, Decoraties gieten met epoxy en Zelf epoxy puzzel maken. Op de adviespagina vind je alle creatieve projecten overzichtelijk bij elkaar.
Inschrijven voor de epoxy workshop
Wil je deelnemen aan de epoxy workshop? Dat kan zowel met een groep als individueel. Hieronder lees je precies hoe het werkt.
Voor groepen van vier tot zes personen
Wil je samen met vrienden, familie of collega’s een workshop volgen, dan kun je direct een datum reserveren. Groepen worden altijd ingepland zodra er een geschikt moment beschikbaar is.
- Bekijk via de Google boekingspagina welke data beschikbaar zijn. (Zonder ordernummer kan de reservering niet volledig worden afgerond.)
- Plaats vervolgens online jouw bestelling en betaling voor de workshop.
- Met het ordernummer dat je ontvangt kun je in de Google boekingspagina jouw reservering definitief maken.
Groepen van vier tot zes personen kunnen altijd direct boeken, omdat een volledige groep automatisch wordt ingepland.
Voor individuele deelnemers
Kom je alleen of met zijn tweeën, dan kun je je aanmelden via het aanmeldformulier. Epoxywinkel kijkt daarna of er genoeg aanmeldingen zijn om een groep te vormen.
- Je schrijft je in via het aanmeldformulier.
- Zodra er voldoende aanmeldingen zijn, ontvang je een datumprikker om de beschikbaarheid af te stemmen.
- De workshop wordt ingepland wanneer er minimaal vier en maximaal zes deelnemers zijn.
Daarna ontvang je:
- Een betaallink om je deelname te bevestigen.
- Na betaling automatisch een Google Calendar-uitnodiging met alle details.
Heb je vragen over de epoxy workshop?
Neem dan gerust contact met ons op. Je kunt ook onze adviespagina bekijken voor extra tips en inspiratie.